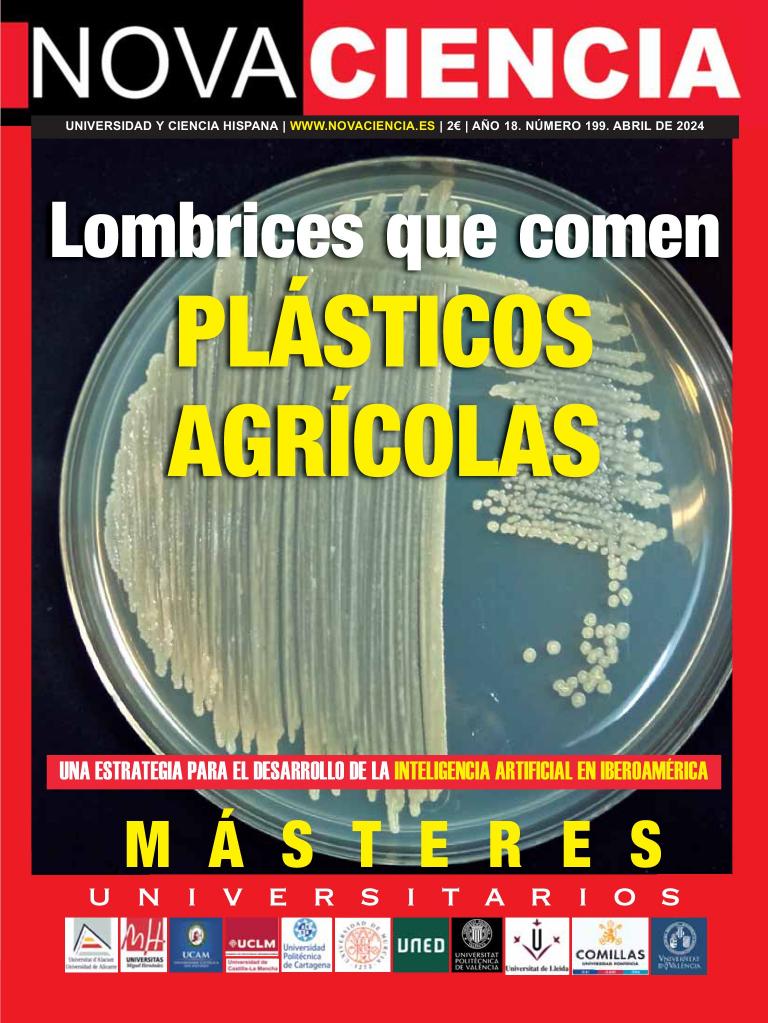

Issue 159 | May 2026
HISTORY OF WAR
Issue:
Nova Ciencia es una publicación de actualidad universitaria y divulgación científica.

Issue 159 | May 2026
HISTORY OF WAR

VISI 144 | May 2026
VISI

May 2026 | May 2026
UDBODHAN

July 2026 | May 2026
HOMES & ANTIQUES

June 2026 | May 2026
BBC SKY AT NIGHT MAGAZINE

June 2026 | May 2026
BBC SCIENCE FOCUS

Issue 274 | May 2026
CóDIGO CERO

Apr 2026 | May 2026
CXO INSIGHT MIDDLE EAST

May 2026 | May 2026
ERGOTHERAPIE UND REHABILITION

May 2026 | May 2026
URBAN MAGAZINE